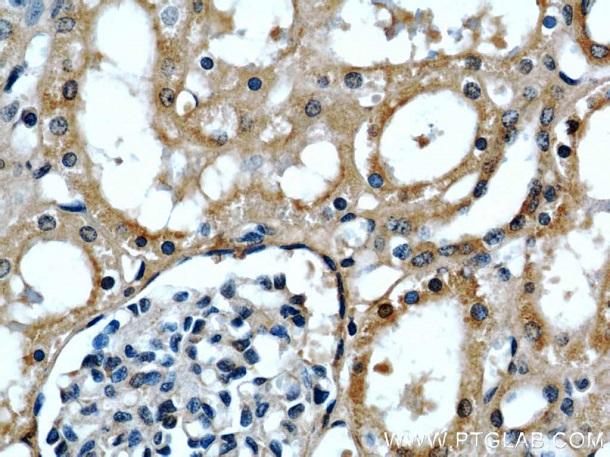

腎臓癌研究に有用な注目マーカー抗体をご紹介いたします。
注目マーカー抗体をご紹介 腎臓癌研究・解析
背景
■ 腎臓癌について
腎臓癌には様々な種類があります。最も多いものが腎細胞癌(RCC:Renal cell carcinoma)です。腎細胞癌は放射線や化学療法に対する耐性があり、外科的手術が最も有望な治療法です。腎細胞癌は、全ての癌の2〜3%を占め、欧米諸国で最も発生率の高い癌です。
■ 注目ターゲット
1. APOL1 | 腎疾患における新たな役割が注目されているターゲット
アポリポタンパク質L(ApoL1)の機能変化は、異なる脂質障害を引き起こすことで知られていました。近年発表されたいくつかの研究では、ApoL1タンパク質が異なる腎臓疾患に関与していることが報告されています(1、2、3、4)。
APOL1抗体(品番:11486-2-AP、希釈倍率 1:50)を用いた、ヒト腎臓(パラフィン包埋切片)の免疫組織化学染色(40X)。
| 品番 | 11486-2-AP |
|---|---|
| タイプ | ウサギポリクローナル |
| 適用 | ELISA、IHC(免疫組織化学)、FC(フローサイトメトリー)、IF(免疫蛍光染色)、IP(免疫沈降)、WB(ウェスタンブロット) |
| 交差種 | ヒト、マウス、ゼブラフィッシュ |
2. SIX2 | 腎臓組織の発生への関与で注目されているターゲット
SIX2は、腎臓分化を含む間葉系組織の発生において発現することが報告されています。また、SIX2は、腎前駆細胞(renal progenitor cells)を顕著に標識するため、尿管芽(UB:ureteric bud)と腎臓におけるcap mesenchyme(CM)間を区別する強力なツールとして有用です(5)。

SIX2抗体(品番:11562-1-AP)を用いた、マウス胎児腎臓組織(E13.5で解剖後、2日間培養)の蛍光免疫染色(by Dr. Aleksandra Rak-Raszewska)。
| 品番 | 11562-1-AP |
|---|---|
| タイプ | ウサギポリクローナル |
| 適用 | ELISA、IHC(免疫組織化学)、IF(免疫蛍光染色)、IP(免疫沈降)、WB(ウェスタンブロット)、ChIP(クロマチン免疫沈降)、プルダウン |
| 交差種 | ヒト、マウス、ラット、American alligator |
3. CA9 | 診断、予後および治療のためのマーカー
CA9(炭酸脱水酵素9)は、炭酸脱水酵素の膜貫通型ファミリーです。CA9は、腎細胞癌に特異的なマーカーです。CA9は正常な腎組織では発現しませんが、ほとんどの腎明細胞癌(clear cell renal cell carcinomas)で発現することが示されています(6、7)

CA9抗体(品番:66243-1-IG、希釈倍率:1:400)を用いた、ヒト腎細胞癌(パラフィン包埋切片)の免疫組織化学染色(40X)。
| 品番 | 66243-1-Ig |
|---|---|
| タイプ | マウスモノクローナル |
| 適用 | ELISA、IHC(免疫組織化学)、IF(免疫蛍光染色)、WB(ウェスタンブロット) |
| 交差種 | ヒト、マウス、ブタ |
| 抗体名 | 品番 | タイプ |
|---|---|---|
| CA2 | 16961-1-AP | ウサギポリクローナル |
| Calbindin | 14479-1-AP | ウサギポリクローナル |
| GSTT1 | 15838-1-AP | ウサギポリクローナル |
| NKCC2 | 18970-1-AP | ウサギポリクローナル |
| PDK1 | 18262-1-AP | ウサギポリクローナル |
| Renin | 14291-1-AP | ウサギポリクローナル |
| Synaptopodin | 21064-1-AP | ウサギポリクローナル |
| VEGF | 19003-1-AP | ウサギポリクローナル |
- Tzur S, et al. Human Genetics, 2010; 128: 345–50.
- Behar D, et al. Am J Kidney Dis, 2006; 47: 88–94.
- Lan X, et al. Experimental and Molecular Pathology 2015; 98: 491–501.
- Hu C, et al. FEBS Lett. 2012; 586: 947–55.
- Short K, et al. Developmental Cell, 2014; 29: 188–202.
- Tostain J, et al. Eur J Cancer. 2010; 46: 3141–8
- Soyupak B, et al. Urol Int. 2005; 74: 68–73.
| 品名 | メーカー | 品番 | 包装 | 希望販売価格 |
|---|---|---|---|---|
Anti CA2, Human (Rabbit) Unlabeled![]() |
PGI | 16961-1-AP | 150 UL |
¥67,000 |
Anti Calbindin-D28k, Human (Rabbit) Unlabeled![]() |
PGI | 14479-1-AP | 150 UL |
¥67,000 |
Anti GSTT1, Human (Rabbit) Unlabeled![]() |
PGI | 15838-1-AP | 150 UL |
¥67,000 |
Anti SLC12A1/NKCC2, Human (Rabbit) Unlabeled![]() |
PGI | 18970-1-AP | 150 UL |
¥67,000 |
Anti PDK1, Human (Rabbit) Unlabeled![]() |
PGI | 18262-1-AP | 150 UL |
¥67,000 |
Anti Renin, Human (Rabbit) Unlabeled![]() |
PGI | 14291-1-AP | 150 UL |
¥67,000 |
Anti SYNPO, Human (Rabbit) Unlabeled![]() |
PGI | 21064-1-AP | 150 UL |
¥67,000 |
Anti VEGFA, Human (Rabbit) Unlabeled![]() |
PGI | 19003-1-AP | 150 UL |
¥67,000 |
商品は「研究用試薬」です。人や動物の医療用・臨床診断用・食品用としては使用しないように、十分ご注意ください。
※ 表示価格について






















このページを印刷する










